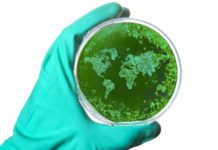
Antibiotikaresistens var vanligast i Ryssland världen medicin antibiotika storliten

Efter Rysslands invasion av Ukraina har exporten av den ryska naturgasen till Europa minskat. Om Ryssland helt skulle stoppa tillförseln skulle det få stora konsekvenser för många samhällskritiska verksamheter. En av dessa är läkemedelsförsörjningen eftersom naturgas behövs vid produktion av läkemedel. Ökade bränslepriser och en eventuell energiransonering skulle också slå mot distributionen av läkemedel.
Potentiell brist på naturgas diskuteras i EU
Enligt Bengt Mattson, sakkunnig på läkemedelsindustriföreningen Lif och dess representant i nätverket ADL, är detta ett problem som diskuteras både inom Sverige och EU. ADL, som står för Aktörsgemensamt dialogmöte om läkemedelstillgänglighet, startade under pandemins första månader och har som syfte att öka beredskapen inom läkemedelssektorn och trygga tillgången till läkemedel.
Efter den ryska invasionen gjorde ADL en riskanalys under ledning av Sveriges regioner, där en av de identifierade riskerna var just en potentiell energikris.
– Vi har inte något konkret exempel på att de minskade gasleveranserna har orsakat någon läkemedelsbrist i nuläget. Men ett totalt stopp av exporten av rysk naturgas skulle få konsekvenser för både produktionen och distributionen av läkemedel och även för energiförsörjningen inom hälso- och sjukvården, säger Bengt Mattson.
När skulle ett sådant potentiellt stopp märkas på läkemedelsförsörjningen i Sverige?
– Skulle vi få en energikris på allvar så finns det ett läkemedelslager hos leverantörerna som skulle räcka i tre till fyra månader med en normalkonsumtion. Sedan finns det också en viss lagerhållning hos apoteken och inom hälso- och sjukvården.
Hur orolig är du?
– Jag tycker att läget oroar. Men även om läkemedelsförsörjningen kan påverkas ser jag inget skäl att vara extra orolig för just den. Där finns det en lagerhållning som gör att vi klarar oss en period. Det är många andra områden som riskerar att påverkas snabbare. Jag vill inte heller göra folk oroliga i onödan eftersom det skulle kunna leda till hamstring av läkemedel.
Bengt Mattson vill inte gå in på i detalj vad man gör för att motverka en energikris, men säger att de bevakar läget.
– Det är alltid svårt att sia om framtiden men vi tittar på hur man kan säkra upp tillgången så gott det går.